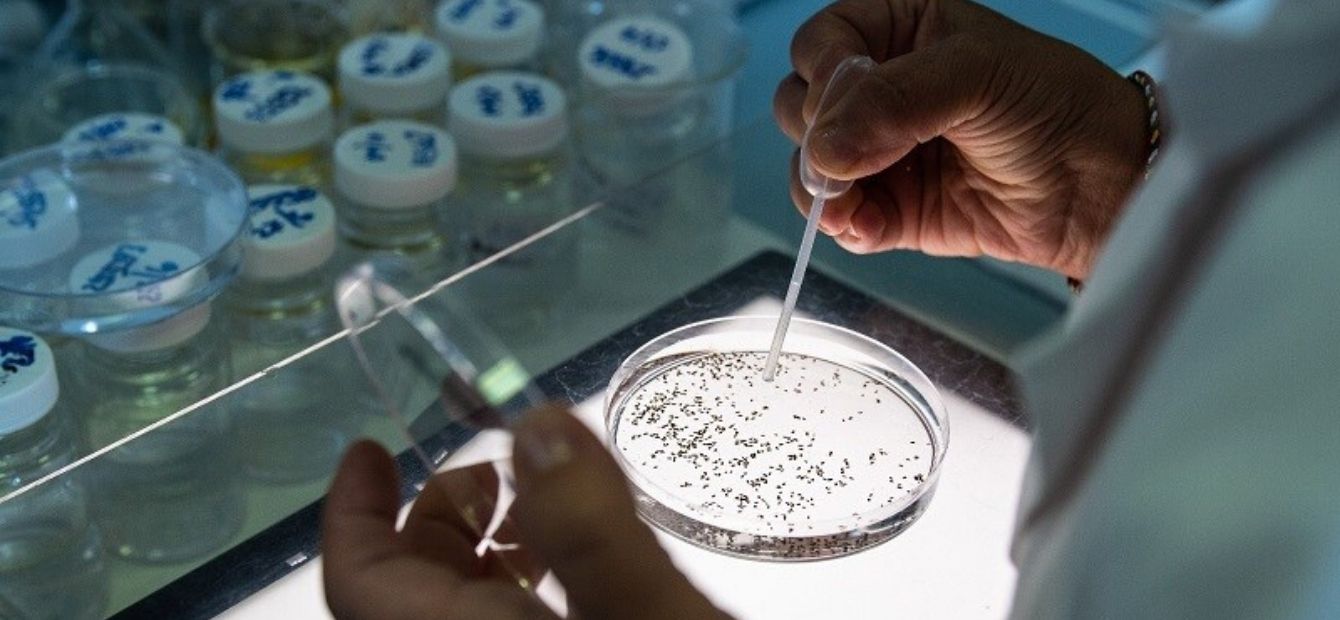
Laboratori Header con immagine e testo

Ci impegniamo ogni giorno per darvi acqua buona e sicura.
Nei nostri laboratori, dislocati sul territorio (Bari, Taranto, Brindisi, Lecce e Foggia) e presso gli impianti di potabilizzazione (Fortore, Sinni, Pertusillo, Conza e Locone), team di biologi, chimici, periti, tecnici ed operatori monitorano costantemente l'intero ciclo dell'acqua.
La purezza e il monitoraggio delle acque sono garantite, inoltre, da stazioni di disinfezione supplementari e da centraline automatizzate, posizionate nei principali nodi della rete.
Ogni giorno sono prelevati campioni dalle sorgenti, dagli invasi, dai pozzi, dalle fontanelle pubbliche e analizzati per garantire un'elevata qualità dell'acqua potabile.
I controlli sulla rete
Negli anni, abbiamo progressivamente aumentato il numero di controlli e il tipo di parametri analizzati. Non ci siamo limitati al solo monitoraggio previsto dalla normativa vigente, ma abbiamo effettuato controlli anche su parametri aggiuntivi.
Inoltre, oggi ci serviamo di un complesso sistema di telecontrollo che, in remoto, ci consente di monitorare alcuni parametri della qualità dell’acqua, che vanno ad integrare i controlli svolti nei nostri laboratori.
Il Piano di Sicurezza dell’Acqua
A partire dagli ultimi mesi del 2018, abbiamo intrapreso un lungo percorso che, con la stipula della convenzione con l’Istituto Superiore di Sanità, ha portato alla redazione di un Piano di Sicurezza (PSA). Il progetto è attualmente in pieno svolgimento. Questo ha portato, nel corso del 2019, a diversi sopralluoghi lungo le filiere idropotabili del Pertusillo e del Fortore assieme al Team Multidisciplinare PSA costituito da Acquedotto Pugliese, Istituto Superiore di Sanità, ARPA Puglia, ARPA Basilicata e Assessorato alla Salute della Regione Puglia.
Le attività proseguiranno, nei prossimi anni, per esaminare anche le altre filiere idriche attraverso le quali AQP fornisce acqua al territorio.
Accreditamento
Alcuni laboratori provinciali sono organizzati come laboratorio “multisito” accreditato in conformità alla norma UNI EN ISO/IEC 17025:2018. In particolare, a seguito delle periodiche verifiche dei team ispettivi di ACCREDIA, le sedi attualmente accreditate sono Bari, Foggia, Lecce e Taranto.
Per avere maggiori informazioni su matrici e prove oggetto dell'accreditamento alla norma ISO 17025 del nostro laboratorio multisito, visita il sito ufficiale di ACCREDIA.